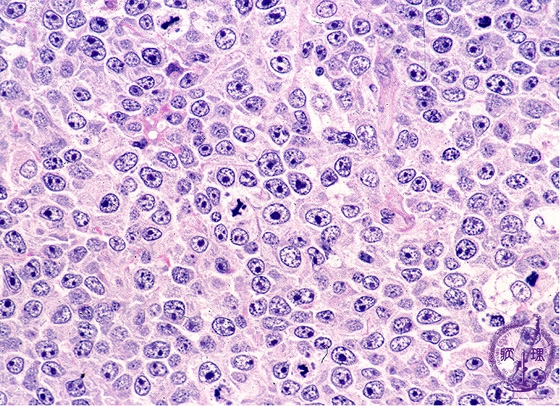
B細胞性慢性リンパ性白血病の症状
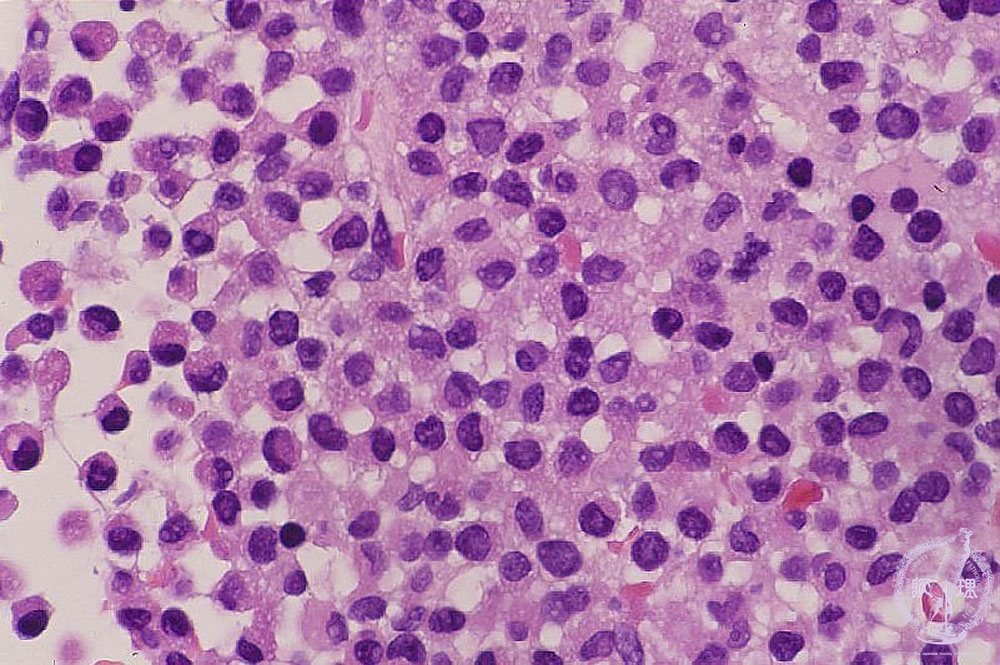
医師の診察を受ける時期

B 細胞性慢性リンパ性白血病 (CLL) は、抗体を作る白血球の一種である B 細胞の異常を引き起こすがんの一種です。
白血病は、血液と骨髄に影響を及ぼす癌の広義の用語です。 B 細胞 CLL は、CLL の最も一般的なタイプです。
この記事では、B 細胞 CLL とは何かを概説し、その症状、原因、合併症、危険因子について説明します。
B 細胞は白血球の一種です。それらは抗体を生成し、免疫システムの一部です。
B細胞は骨髄で発生します。医療専門家は B 細胞を B リンパ球と呼ぶことがあります。
B 細胞 CLL は、異常な B 細胞が過剰に発生するがんの一種です。それは骨髄から始まり、ゆっくりと血液に広がります。
医療専門家は、これらの異常な B 細胞を白血病細胞と呼ぶことがあります。白血病細胞は感染症とうまく戦うことができません。
CLL はまた、これらの白血病細胞の数を血液および骨髄内に増加させ続けます。これは、血液と骨髄に健康な血球が存在する余地が少なくなることを意味します。
慢性リンパ性白血病 (CLL)についてお読みください。
B 細胞 CLL は、初期段階では症状を引き起こさない場合があります。ただし、症状が進行すると、症状が現れ始める場合があります。
がん性 B 細胞が体中に広がると、次のような症状が引き起こされる可能性があります。
これらの癌性 B 細胞の数が多いと、健康な B 細胞の数も減少します。健康な B 細胞が減少すると、感染症と戦う能力が低下する可能性があり、感染症のリスクが高まることを意味します。
医療専門家は、B 細胞 CLL の正確な原因を完全には理解していません。しかし、彼らは、遺伝学がその発生に役割を果たしている可能性があると信じています。
染色体は長い DNA 分子です。細胞が 2 つの新しい細胞に分裂する前に、染色体内に DNA のコピーが作成されます。これが起こると、人の DNA 内の遺伝子に影響を与える可能性のあるエラーが発生する可能性があります。
次のような特定の遺伝子は、細胞の成長と分裂を助ける上で重要な役割を果たします。
- がん遺伝子:細胞の成長と分裂を促進する遺伝子です。
- 腫瘍抑制遺伝子:これらは細胞分裂を遅らせる遺伝子です。また、特定の時間に細胞を死滅させます。
DNA の突然変異によってがん遺伝子がオンになったり、腫瘍抑制遺伝子がオフになったりすると、人はがんを発症する可能性があります。
人間の細胞には 23 対の染色体が含まれています。 CLL のほとんどの場合、医療専門家はこれらの染色体の少なくとも 1 つに変異を観察できます。
科学者は、これらの突然変異が CLL の発症に重要であることを認識しています。しかし、それらがどのようにして症状を発症させるのかは完全には理解されていません。
まれに、特定のがんを発症するリスクを高める可能性のある DNA 変異を親から受け継ぐことがあります。しかし、CLL に関連する DNA 変化はほとんどの場合、その人の生涯の間に発症します。これは、その人が親から DNA 変化を受け継いだものではないことを意味します。
危険因子
B 細胞 CLL の考えられる危険因子は次のとおりです。
- 喫煙
- 特定の化学物質への曝露
- 放射線への曝露
B 細胞 CLL には多くの合併症が考えられます。これらには次のものが含まれます。
がんに関するリソース
がんに関する証拠に基づいた情報とリソースをさらに見つけるには、専用ハブにアクセスしてください。
CLL の考えられる治療法には次のものがあります。
- 化学療法:化学療法治療中、医療専門家はがん細胞の増殖を止める薬を投与します。これは、細胞を殺すか、細胞の分裂を妨げることによって行われます。医療専門家は、これらの薬剤を注射または経口で投与します。
- 放射線療法:放射線療法では、高出力 X 線やその他の種類の放射線を使用して CLL を治療します。これは、がん細胞を殺すか、がん細胞の増殖を阻止することによって行われます。医療専門家は体外の機械を使用して、がん細胞が存在する領域に放射線を送ります。
- 標的療法:標的療法では、がん細胞上の特定のタンパク質を標的とする薬剤を使用します。薬はこれらのがん細胞を破壊したり、その増殖を遅らせたりすることができます。
- 免疫療法:免疫療法は、人の免疫系を利用してがんと闘う治療法です。免疫療法薬は免疫システムを強化し、がんと戦うのに役立ちます。
人が初期段階の CLL に罹患している場合、医療専門家が別の理由で実施した血液検査の結果から CLL を検出する場合があります。
ただし、CLL の症状がある場合は、医療専門家に連絡する必要があります。これらの症状には次のようなものがあります。
- 疲労と衰弱
- リンパ節の腫れ
- 熱
- 継続的な感染症
- あざや出血が起こりやすい
- 原因不明の体重減少
- 寝汗
慢性リンパ性白血病の人の平均余命はどれくらいですか?
病気の 5 年相対生存率とは、診断を受けてから少なくとも 5 年生存する人の割合を指します。
国立がん研究所によると、CLL の 5 年相対生存率は 88.5% です。
慢性リンパ性白血病は治りますか?
医療専門家は通常、CLL を治すことはできません。しかし、CLL 患者の多くは長生きできます。
CLL の早期治療は長生きに役立たない可能性があり、特定の副作用を引き起こす可能性があります。このため、医療専門家は、CLL の治療を開始する前に、がんによってさらに重篤な症状が生じるまで待つことを勧めることがよくあります。
B 細胞 CLL は、免疫機能に不可欠な白血球の一種である B 細胞に影響を及ぼすがんの一種です。
B 細胞 CLL は、異常な B 細胞が骨髄および血液に蓄積すると発生します。これにより、感染症と戦う体の能力が損なわれ、健康な血球が締め出されます。
CLL の症状には、疲労、リンパ節の腫れ、感染症のリスクの増加などが含まれる場合があります。
医療専門家は CLL の正確な原因を知りませんが、遺伝子変異と特定の化学物質への曝露が CLL の発症に寄与している可能性があります。
CLL の合併症には、感染症の増加、免疫系障害、他のがんのリスクの増加などが含まれる場合があります。
治療の選択肢には、化学療法、放射線療法、標的療法、免疫療法などがあります。
B細胞性慢性リンパ性白血病について知っておくべきこと・関連動画
参考文献一覧
- https://www.cancer.gov/publications/dictionaries/cancer-terms/def/five-year-survival-rate
- https://seer.cancer.gov/statfacts/html/clyl.html
- https://www.cancer.org/cancer/types/chronic-lymphocytic-leukemia/treating/treatment-by-risk-group.html
- https://www.ncbi.nlm.nih.gov/books/NBK470433/
- https://www.cancer.gov/publications/dictionaries/cancer-terms/def/b-cell
- https://www.cancer.org/cancer/types/chronic-lymphocytic-leukemia/causes-risks-prevention/what-causes.html
- https://www.cancer.gov/types/leukemia/patient/cll-treatment-pdq